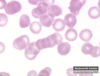
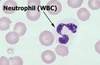
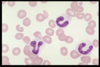

Hematology Review Flashcards
(106 cards)
What is hematopoiesis?
Is the formation and development of blood cells
Where does hematopoiesis take place in a fetus?
Liver
Where does hematopoiesis take place in adults?
bone marrow
What is a erythrocyte?
RBC
What are the five stages of RBC maturation?
Rubriblast Prorubricyte Rubricyte Metarubricyte Polychromatophil
What are the four stages of eosinophil maturation?
Eosinophilic Myelocyte Eosinophilic Metamyelocyte Eosinophilic Band Eosinophil
What are the four stages of neutrophil maturation?
Neutrophilic Myelocyte Neutrophilic Metamyelocyte Neutrophilic Band Segmented Neutrophil
What are the four stages of basophil maturation?
Basophilic Myelocyte Basophilic Metamyelocyte Basophilic Band Basophil
What are the three stages of monocyte maturation?
Monoblast Promonocyte Monocyte
What are the three stages of lymphocyte maturation?
Lymphoblast Prolymphocyte B and T Lymphocytes
What are the four stages of platelet maturation?
Megakaryoblasts Promegakaryocytes Megakayocytes Platelets
Do you get plasma or serum in a purple top tube?
Plasma
What anticoagulant is in a purple top tube?
EDTA
What are purple top tubes commonly used for?
CBC’s and Platelet counts
Do you get plasma or serum in a green top tube?
Plasma
What anticoagulant is in a green top tube?
Lithium Heparin
What are green top tubes commonly used for?
blood chemistries, electrolytes, and stats
What anticoagulant is in a red top tube?
no additive
Do you get plasma or serum in a red top tube?
serum
How long must a red top tube sit before centrifugation?
15-30 minutes
What are red top tubes commonly used for?
chemistries and serological assays
If the serum isn’t removed immediately what can it effect?
Blood glucose
Do you get plasma or serum in a tiger/marble top tube?
serum
What anticoagulant is in a tiger/marble top tube?
no additive but does have a silicon gel